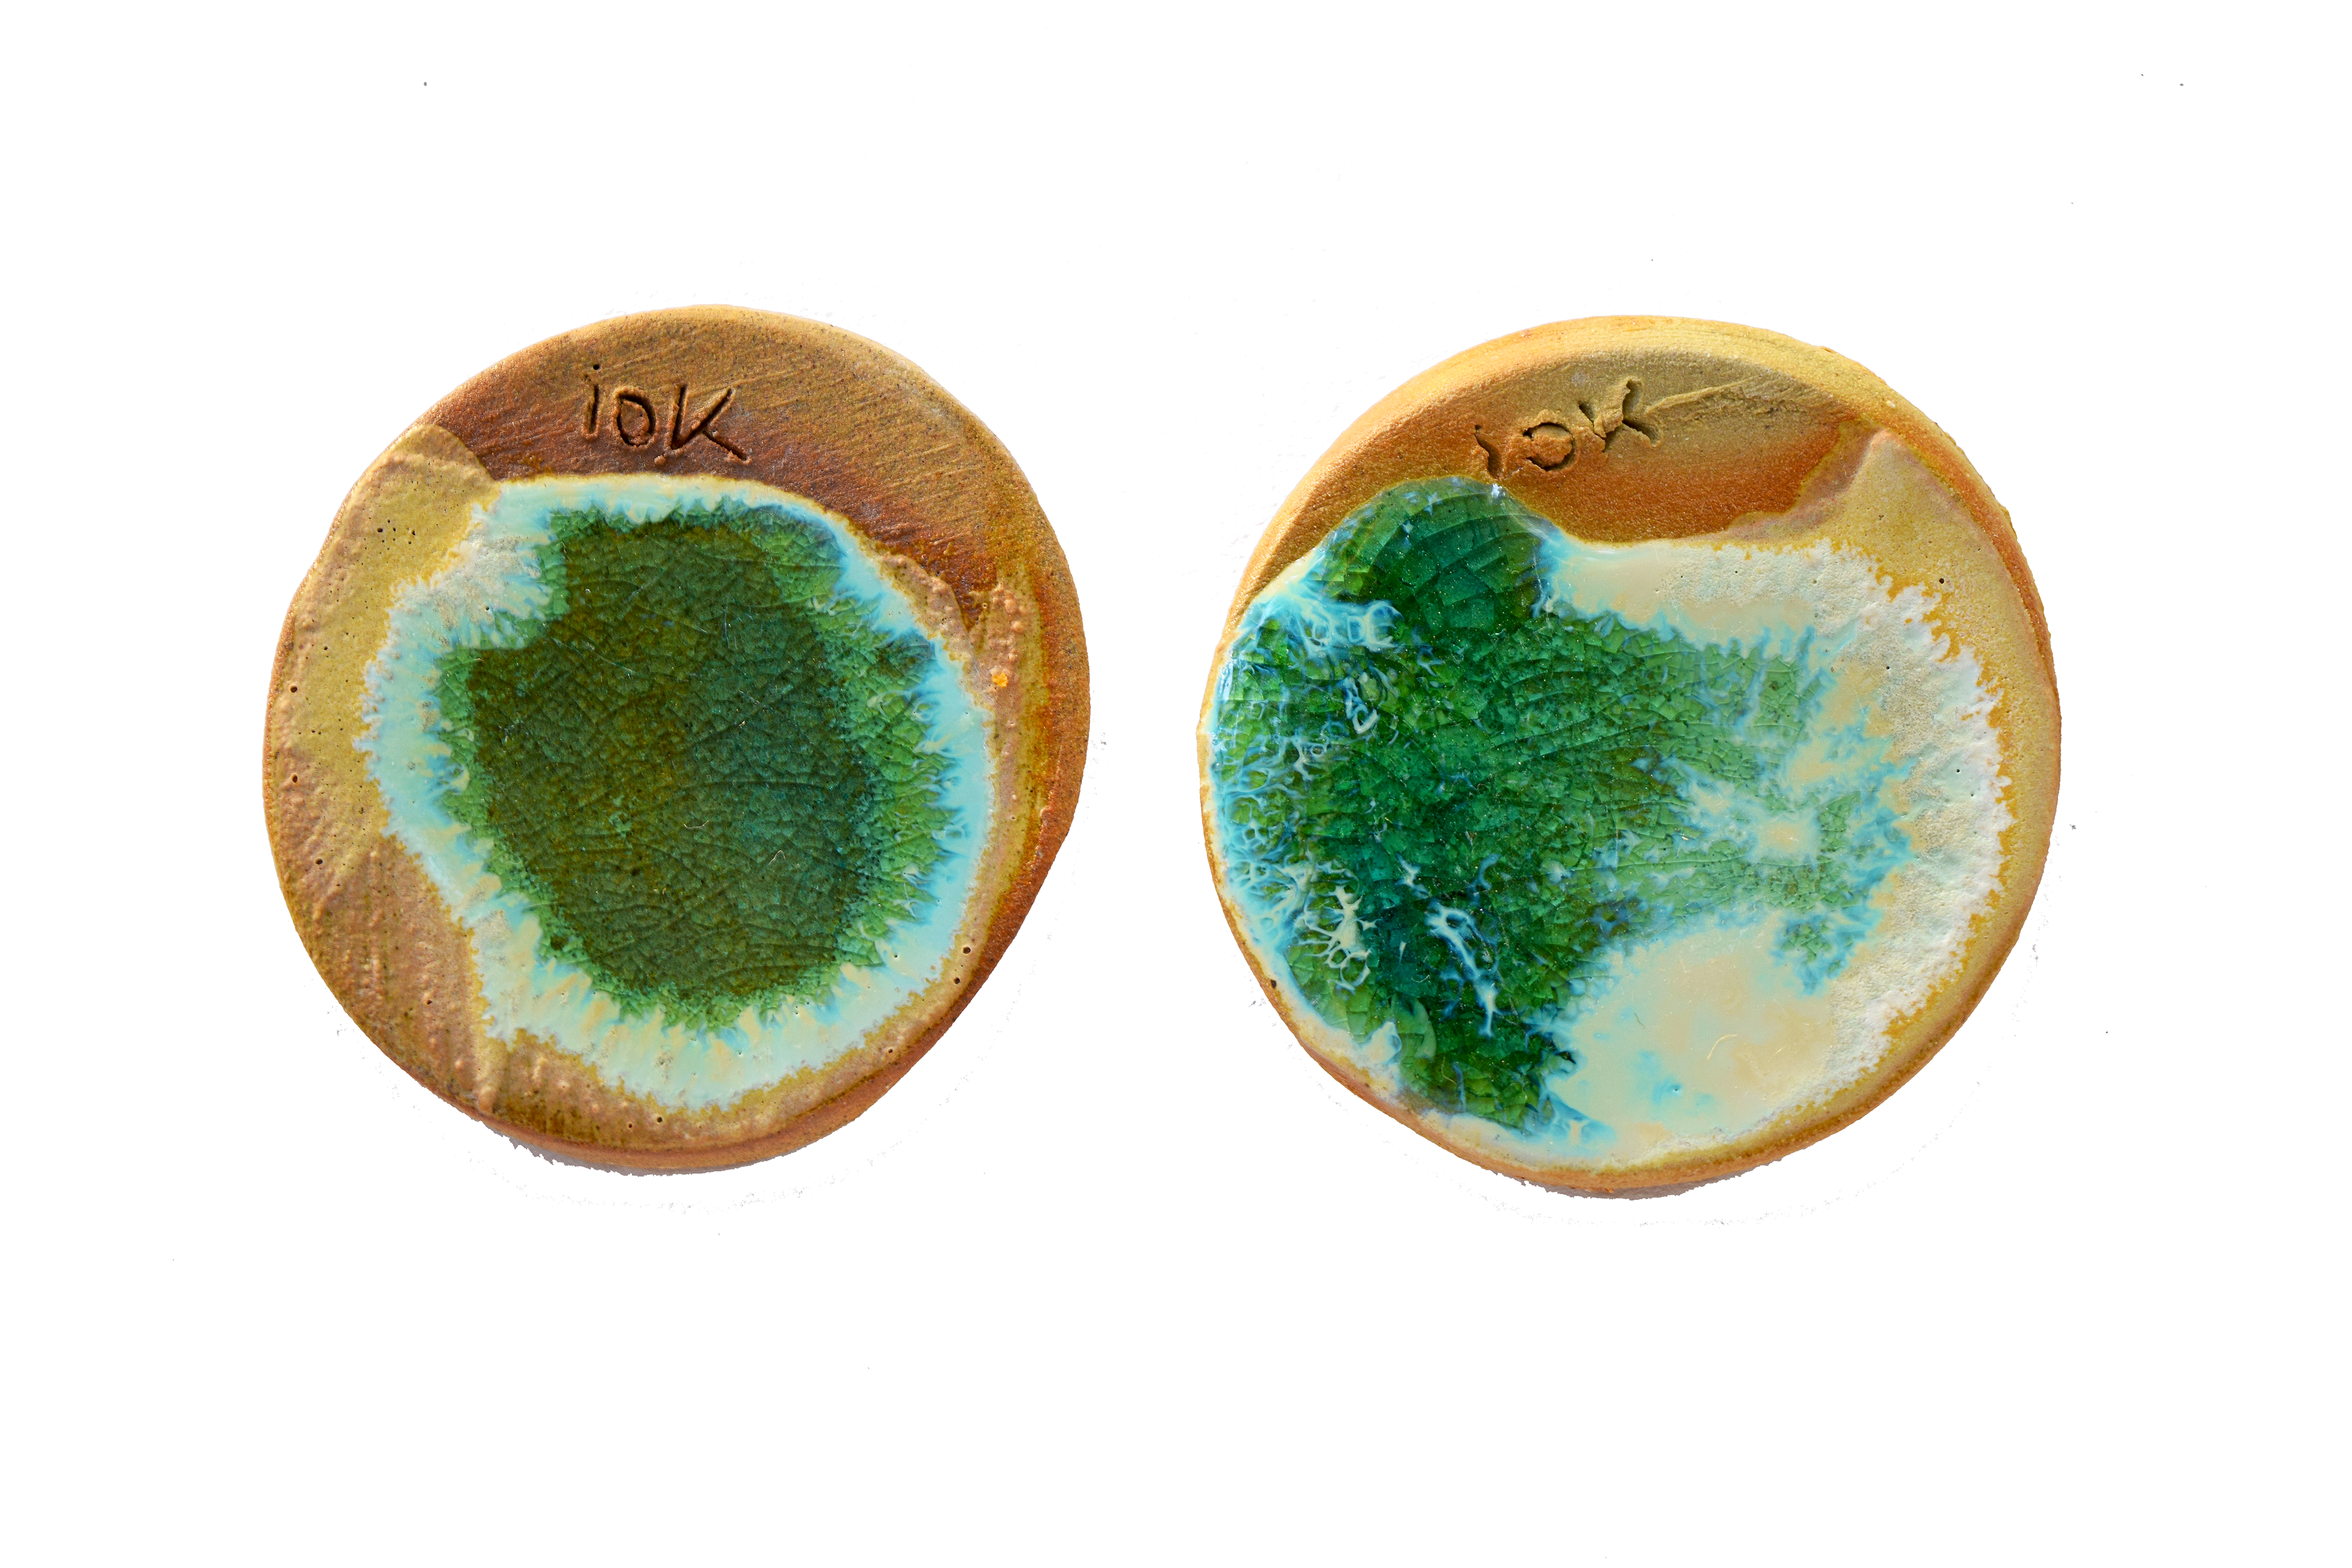

J'ai appris à travailler les émaux lors de mes études et de mes stages. La recherche d'émaux est ce qui m'a lié le plus fortement à la pratique de la céramique, la recherche chimique et ses découvertes est exaltantes. Je fais évoluer mes recettes au cours des années et la découverte est infinie.